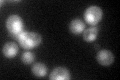
YNL180C
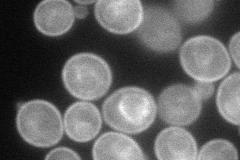
YNL180C
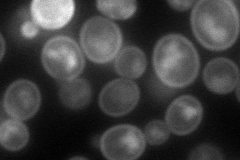
YNL180C
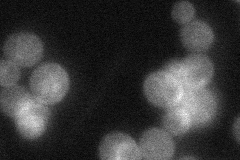
YNL180C
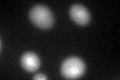
YNL180C
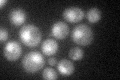
YNL180C
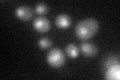
YNL180C

View description
Non-essential small GTPase of the Rho/Rac subfamily of Ras-like proteins, likely involved in protein kinase C (Pkc1p)-dependent signal transduction pathway that controls cell integrity
Localization:
Intensity:
Fold change:
Significance:
-
C’ GFP library in SD
nucleus:cytosol43.08 -
N' NOP1pr-GFP in SD
cell periphery,vacuole membrane75.9972 -
N' TEF2pr-mCherry in SD
cell periphery,vacuole80.9852 -
N' NATIVEpr-GFP in SD
cell periphery27.0267 -
N' TEF2pr-VC and Cyto-VN in SD

#N/A0 -
C’ GFP library in SD+DTT
nucleus.cytosol39.650.92No -
C’ GFP library in SD+H2O2
nucleus.cytosol42.150.97No -
C’ GFP library in Starvation Media
nucleus,cytosol71.541.66Yes -
C’ GFP library on the background of Pup2-DaMP

nucleus:cytosol -
C’ GFP library on the background of CCT mutant

nucleus:cytosol37.86050.878601No
